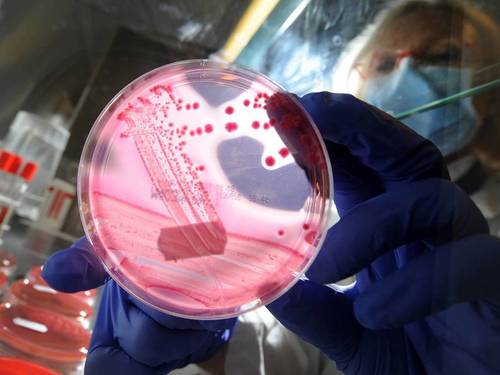

CATEGORÍA: Salud
Yolanda Barcina ingresa en la Real Academia de Farmacia
20 febrero 2017
La ex presidenta de Navarra, catedrática de Nutrición y Bromatología, defendió en su discurso un modelo sostenible de desarrollo
Sanofi y Cinfa, en cabeza de las ventas de medicamentos de marca y genéricos
15 febrero 2017
Los fármacos para el colesterol y la diabetes lideran la tabla en España.
Los secretos del microbioma humano
10 febrero 2017
Una nueva técnica genómica descubre funciones vitales entre los billones de bacterias que viven en nuestro intestino
Más de 200 expertos analizan los avances en las vacunas
10 febrero 2017
IV Jornada de Avances en Vacunas organizada por la Sociedad Española de Pediatría Extrahospitalaria y Atención Primaria (Sepeap).
El sexto hospital privado de Valencia abrirá a partir de la semana que viene
09 febrero 2017
El centro sanitario IMED construido en Burjassot será el tercero en la Comunitat de la firma nacida en Alicante

Farmacias abiertas y de urgencia más cercanas
Farmacias abiertas y de urgencia más cercanas